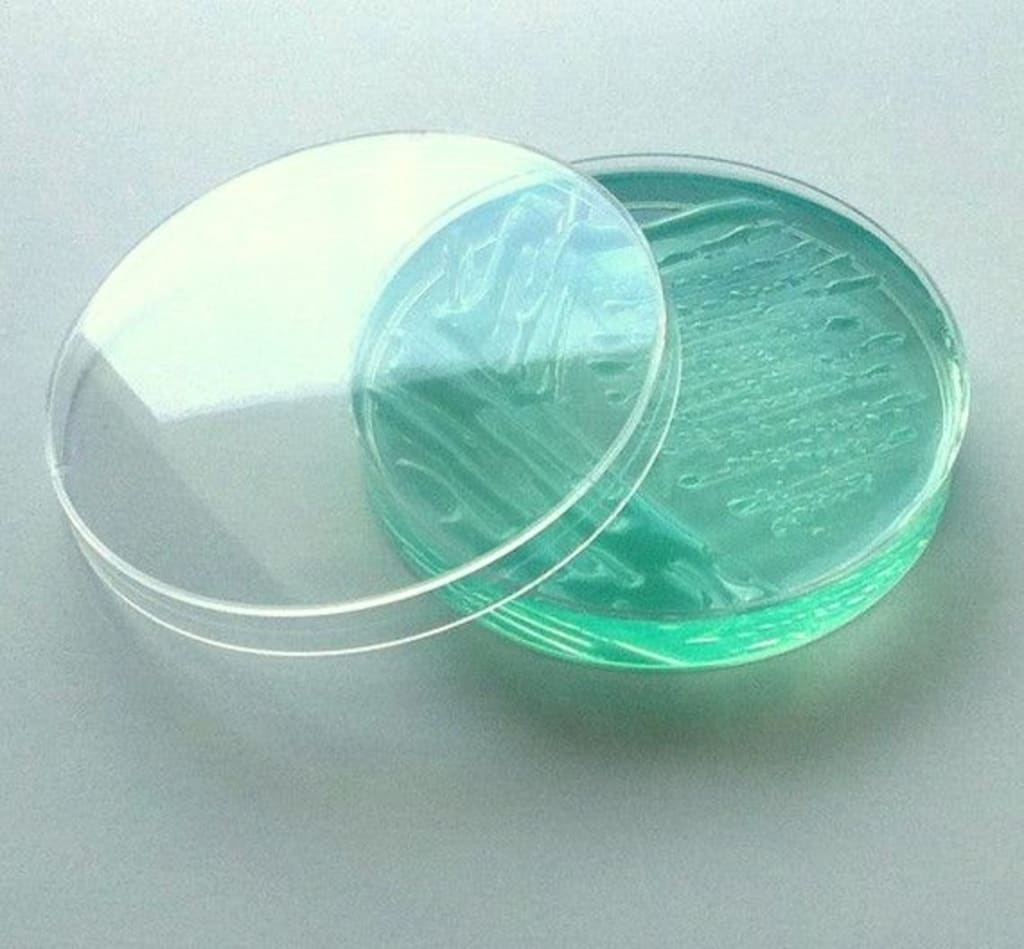

The Growth of Petri Dish as a Tool for Scientific Discovery
Petri Dish
The Origins
Petri dishes have come a long way since their invention in the late 19th century. Named after German bacteriologist Julius Richard Petri, they consists of a shallow glass or plastic circular container with a lid. Its basic design makes it ideal for growing microorganisms and studying bacterial growth in a controlled environment. When Petri developed the dish in 1887, it allowed scientists to culture organisms on solid substrates like gelatin or agar, which became a major breakthrough for isolating and analyzing bacteria. Prior methods involved using liquid cultures, which made it difficult to isolate pure colonies of microbes. With the Petri dish, colonies could be grown, counted, and examined without overlapping or mixing with others.
Widespread Adoption in Medical and Industrial Laboratories
It didn't take long for Petri Dish to be adopted widely in hospital, pharmaceutical, and industrial labs for applications like sterility testing of medical devices, studying mechanisms of antibiotic resistance, and optimizing fermentation processes. The ability to count bacterial colonies allowed scientists to quantify microbial populations and determine efficacy of interventions like sterilization or antimicrobial treatments. In healthcare settings, significant advances were made in controlling infections as techniques like aseptic processing and quality control testing of medical products relied on precise observation using Petri dishes. Industries also gained insights into improving production processes by monitoring fermentations and contamination issues. Standardized testing methods utilizing them boosted confidence in product quality and consistency.
Advances in Materials and Automation
While the basic design remains unchanged, Petri dishes have evolved in important ways over the decades. The original glass dishes proved fragile and impractical for mass experiments. Plastics like polystyrene eventually replaced glass as the preferred material due to its durability, autoclavability, and optical clarity. Modified plastic surfaces also allow culturing different types of microbes. Automated colony counters, incubators, and storage systems now handle tasks once done manually. Advanced imaging software analyzes digital photographs of plated samples, automating documentation and saving labor. These advances boosted experimental throughput and reproducibility. Moreover, multi-well microplates holding thousands of individual samples in a single dish paved the way for high-throughput screening methods vital to drug discovery.
Continued Innovation and Medical Applications
Today they remain indispensable tools enabling new scientific insights across diverse disciplines. Researchers leverage cutting-edge techniques pairing traditional culturing with genomic analysis to tackle pressing problems. For example, clinical microbiologists use whole genome sequencing of colonies grown in Petri dishes to track outbreak sources and emergence of antimicrobial resistance in near real-time. A resurgence in phage therapy revived interest in isolating and studying bacteriophages on Petri plates. Environmental scientists rely on culturing techniques to characterize microbiomes and analyze impacts of contaminants. Tissue engineers develop novel biomaterials by observing cellular behavior and interactions cultured on modified Petri surfaces. Thanks to its simple but elegant design paired with ongoing innovations, the iconic Petri dish remains at the forefront of scientific discovery well over a century since its invention.
Identify the language that you favour-
• French
• German
• Italian
• Russian
• Japanese
• Chinese
• Korean
• Portuguese
About Author-
Ravina Pandya, Content Writer, has a strong foothold in the market research industry. She specializes in writing well-researched articles from different industries, including food and beverages, information and technology, healthcare, chemical and materials, etc. With an MBA in E-commerce, she has an expertise in SEO-optimized content that resonates with industry professionals. (https://www.linkedin.com/in/ravina-pandya-1a3984191)
___________________________________________________________________________________ V6 ___________________________________________________________________________
The History and Significance of Petri Dishes
The Origins
Petri dishes were invented in the late 19th century by German bacteriologist Julius Richard Petri. As a microbiologist studying at the University of Berlin, Petri was looking for a better way to grow bacteria and observe microbial colonies. In 1887, he designed a shallow, circular glass container with a cover that allowed visibility from both the top and bottom. This novel design provided scientists with an improved system for studying microbial growth on solid surfaces under controlled laboratory conditions. Petri's invention revolutionized the study of microbiology and helped advance scientific understanding of infectious diseases.
Preparing Nutrient Agar Plates
To use a Petri Dish properly, it must first be prepared with a sterile growth medium. The most common medium is nutrient agar, a jellified mixture of nutrients and water that provides microorganisms with food and moisture. The agar sets into a solid gel that supports colony growth. Scientists sterilize agar by autoclaving it at high temperatures to kill any contaminating microbes. Once cooled but still in liquid form, the agar is poured into the sterile Petri dishes under aseptic conditions to prevent contamination. The agar solidifies as it cools, forming a flat surface.
Observing Colony Morphology
They allow scientists to isolate single microbial cells and observe how they grow and interact. When microbes are streaked or dotted onto the surface of nutrient agar, each one founders its own colony. Over the course of several days, these colonies multiply and spread. Their shape, size, color, texture and other distinguishing characteristics are known as colony morphology. By examining morphological differences between colonies, researchers can gain insights into microbial taxonomy, physiology, metabolism and more. Colonies may be circular, filamentous, punctiform or have irregular margins depending on species and growing conditions.
Detecting Microbial Contamination
A key application of the Petri dish technique is for microbiological quality control testing. Food, water, pharmaceutical and other manufactured products are routinely analyzed for contaminants using agar plate methods. Samples are obtained, diluted if necessary, and plated by spreading or streaking aliquots on selective and differential agars. These agars are formulated to encourage or inhibit the growth of target vs. non-target microbes. After incubation, the number and types of colonies provide a quantitative and qualitative assessment of microbial load and safety. They enumerate bacteria, mold and yeast colonies with ease, allowing contaminants to be detected even when present in very small amounts.
Antibiotic Susceptibility Testing
In the medical field, they play an important role in antimicrobial susceptibility testing to determine effective antibiotic treatment options. A lawn of bacterial growth is established by flooding nutrient agar plates with a standardized microbial suspension. Antibiotic discs or strips impregnated with different drugs are applied to the surface. As the antibiotics diffuse outward, zones of inhibited bacterial growth appear around each disc after overnight incubation. The size of these zones corresponds to an organism's sensitivity or resistance to that particular antibiotic. This disk diffusion method guides empiric antibiotic therapy for infectious diseases.
Limitations of the Petri Dish Technique
While revolutionary in its time, they does have some limitations. It only supports the growth of microbes able to thrive on solid surfaces aerobically. Fastidious organisms requiring special nutrients, anaerobic environments or attachment/ biofilm substrates cannot always be reliably cultured. Some microbes may enter a viable but non-culturable state rather than forming colonies. Petri dishes likewise fail to capture microbial interactions that occur in complex, three-dimensional communities rather than as isolated colonies. Advances in microscopy, molecular techniques and microfluidic systems now complement traditional agar plating by offering new insights into these uncultured and community-level dynamics. Nonetheless, the simple yet highly effective Petri dish design perfected by Julius Petri over 130 years ago remains the cornerstone of microbiology even today.
Identify the language that you favour-
• French
• German
• Italian
• Russian
• Japanese
• Chinese
• Korean
• Portuguese
About Author-
Ravina Pandya, Content Writer, has a strong foothold in the market research industry. She specializes in writing well-researched articles from different industries, including food and beverages, information and technology, healthcare, chemical and materials, etc. With an MBA in E-commerce, she has an expertise in SEO-optimized content that resonates with industry professionals. (https://www.linkedin.com/in/ravina-pandya-1a3984191)




Comments
There are no comments for this story
Be the first to respond and start the conversation.